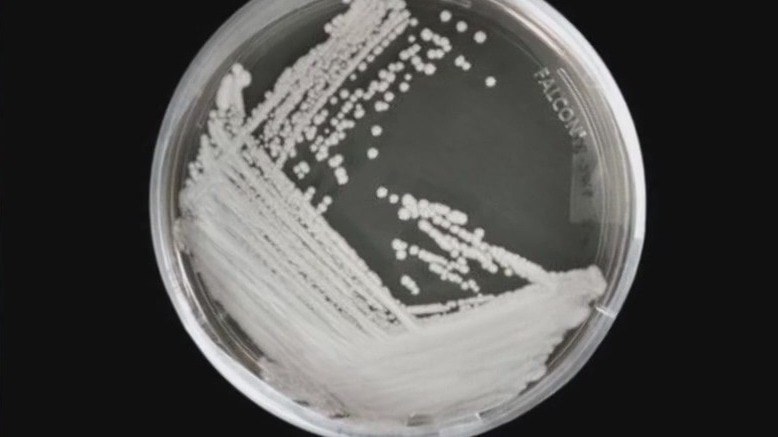

CDC: Fungal infection spreading at alarming rate
A deadly fungus outbreak is becoming an urgent public health threat, according to the CDC. Dr. Luis Ostrosky Chief of Infectious Diseases and Epidemiology with UTHealth Houston and Memorial Hermann explains what we need to know.

